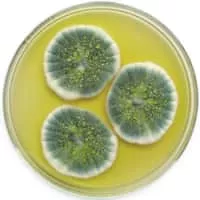
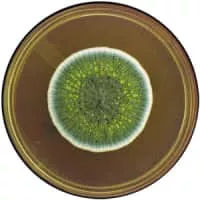

Penicillium Chrysogenum
| Use attributes for filter ! | |
| Kingdom | Fungi |
|---|---|
| Class | Eurotiomycetes |
| Order | Eurotiales |
| Family | Trichocomaceae |
| Scientific name | Penicillium chrysogenum |
| Did you know | Penicillium chrysogenum (also known as Penicillium notatum) is the source for penicillin, the first antibiotic. |
| Date of Reg. | |
| Date of Upd. | |
| ID | 952054 |
About Penicillium Chrysogenum
Penicillium chrysogenum or P. notatum is a species of fungus in the genus Penicillium. It is common in temperate and subtropical regions and can be found on salted food products, but it is mostly found in indoor environments, especially in damp or water-damaged buildings.